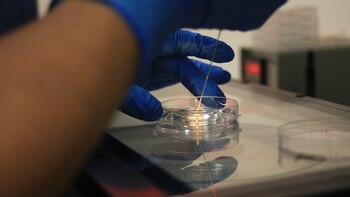
Investigadores piden armonizar en Europa

Cuáles son las claves en tecnología genética detrás del nacimiento de ocho bebés libres de enfermedades hereditarias
El proceso desarrollado en la Universidad de Newcastle combina material genético de padres y donante para frenar las mutaciones mitocondriales, abriendo oportunidades en la fecundación in vitro

Saskia Niño de Rivera revela que su hermano es el padre biológico de uno de sus hijos y divide opiniones
La activista compartió detalles de su segundo embarazo en una charla con la actriz Aislinn Derbez

Prueba de ADN no es válida para refutar la paternidad o maternidad: esto determinó la Corte Suprema
La alta corte tomó la decisión luego de estudiar un caso de gestación con reproducción asistida

Michelle Renaud confiesa que se embarazó por fecundación in vitro; revela el sexo del bebé que espera junto a Matías Novoa
Los actores se encontraban en planes de boda cuando se enteraron que estaban esperando un bebé

Investigadores piden armonizar en Europa el control de unas enfermedades sexuales en auge
Isabel Zapata y su libro sobre la infertilidad: “No poder concebir es vergonzoso, te sientes como fallida”
Entrevista con la escritora mexicana autora de “In Vitro”, en el que narra su experiencia con un tratamiento de fertilización asistida por el que fue madre y reflexiona sobre las relaciones entre el deseo, la ciencia y la maternidad

Hizo un tratamiento de fertilidad y la felicitaron por partida doble: la madre soltera que es viral en TikTok
María Paula Rodríguez Iglesias había perdido un embarazo gemelar y quiso volver a intentar ser mamá, pero esta vez sería sola. Ya no tenía pareja. Averiguó cómo podría hacer un tratamiento de fertilidad por medio de su obra social, con donante, para tener ese hijo que había soñado. Pero llegaron dos varones que le cambiaron la vida y enternecieron a los usuarios de TikTok

Pese a estar en la menopausia, logró tener un bebé: es abuela y le ganó a “lo imposible”
Myrian Arias tenía 37 años y todavía trabajaba como empleada doméstica cuando empezó a buscar un embarazo. La médica, sin embargo, le dijo “te acordaste tarde”. Myrian lloró, sufrió y hasta le dijo a su marido que se buscara otra mujer. Hasta que supo que la médica, tal vez por desidia, le había mentido: sí era posible. Pero ¿cómo, si hacía años que no producía óvulos?

Una mujer de 53 años prestó su vientre a su hija para tener a su primer bebé, pero un mes después ella también quedó embarazada
Después de varios intentos fallidos y tres años de infertilidad, una pareja de Minnesota, EEUU, dio la bienvenida a dos bebés

Últimas Noticias
Del boom global de los hongos a un nuevo alimento funcional
Mientras el consumo de hongos crece en todo el mundo por su perfil nutritivo y sustentable, investigadores desarrollan un proceso que permite fortificarlos naturalmente con vitamina D₂
Múltiples fracturas en el cráneo: cómo sigue el hombre de 27 años que volcó con su cuatriciclo en Villa Gesell
El paciente, oriundo de Guernica, permanece en terapia intensiva con respiración asistida y medicación para sostener la presión arterial. Se postergó la operación programada para este lunes por una alteración en la coagulación

Represión en Irán: el régimen amenazó con “castigos decisivos” a los responsables de la ola de protestas que sacude el país
Los ayatollahs justificaron el endurecimiento de la respuesta en supuestos “actos terroristas”, mientras organismos de derechos humanos alertaron sobre miles de detenidos, ejecuciones y un prolongado bloqueo de internet

“Yo no estoy cerrada a ser investigada”: Grecia Quiroz respondió los señalamientos que recibió sobre el asesinato de Carlos Manzo
En la declaraciones señaló que una mujer estaría realizando estas acusaciones con el objetivo de colgarse del Movimiento del Sombrero

Reporte meteorológico: las temperaturas que se esperan en Asunción este 20 de enero
Durante el invierno en Paraguay la temperatura baja hasta los cero grados, siendo -7 grados el récord histórico, ocurrido en el año 2000
